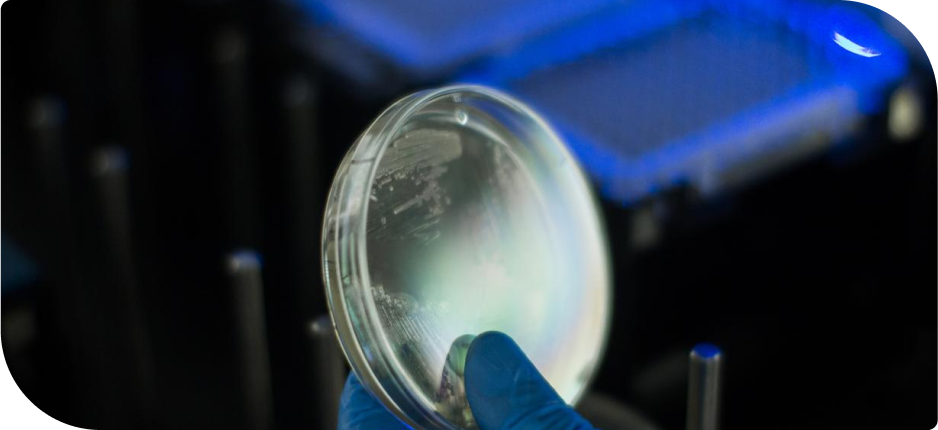
Encontre um Produto

Productos Braskem
Alrededor del mundo, la cartera de químicos y petroquímicos de Braskem ofrece artículos esenciales para las necesidades de las personas en su día a día, en diferentes segmentos del mercado. Nuestras soluciones incluyen una gran variedad de activos para componer el proceso productivo de su empresa y asegurar la calidad de sus productos.
En esta sección encontrará las líneas de productos disponibles en Brasil. Descubra los productos disponibles en otras regiones:
Líneas de Producto
Las soluciones de Braskem están presentes en diferentes momentos de nuestro cotidiano y en diferentes segmentos. Conozca más sobre nuestras resinas, especialidades, solventes y olefinas y aromáticos.
Ver más
Clientes
Junto a nuestros clientes buscamos la sinergia, fomentamos la colaboración, diversificamos y optimizamos conocimientos y recursos, creando un mundo de posibilidades y contribuyendo a la evolución y potenciación de sus negocios.
Ver más


Catálogos
Braskem enfoca sus soluciones en segmentos de mercado y líneas de productos, con carteras integrales de resinas plásticas y productos químicos.
Acceder a catálogos

Sección técnica
Documentos, boletines técnicos, estudios ACV, fichas de producto. Todo en un solo lugar.
Explore nuestrosdocumentos técnicos
Encuentra un produto
Vea las características completas de los productos Braskem.
Búsqueda de Producto
Clientes
Conviértase en cliente de Braskem
Braskem es una de las mayores proveedoras de productos químicos y petroquímicos del mundo, reconocida por su enfoque en el desarrollo sostenible, la innovación y la calidad.
Creemos en las asociaciones duraderas, tenemos una amplia cartera de productos y trabajamos junto con nuestros clientes para crear nuevas soluciones prácticas y sostenibles en todos los mercados.
Contacte nuestro equipo de ventas

Braskem Global
Braskem Idesa
Braskem USA
Braskem Europe